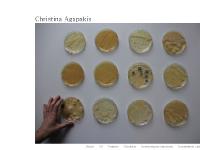
agapakis.com Projects, Hydrocalypse Industries, Icosahedron Labs

Agapae.info
Agapae is ranked > 3,000,000 in the United States. 'Site Suspended - This site has stepped out for a bit.'
--Rank in United States
--Worldwide Rank
| Monthly pages viewed | < 300 | |
| Monthly visits | < 300 | |
| Value per visitor | -- | |
| Estimated worth | $775.94 | |
| External links | 2 | |
| Number of pages | 45 |
Last Updated: 04/15/2018 . Estimated data, read disclaimer.
Content
www.Agapae.info
- Popular pages
- agapae.info BabyGEAR-Baby-Gear-Security-Lovey-Blanket-Pink-Bear-NWT
- agapae.info BNIP-Petit-Tresor-Nesting-4-PIECE-BEDDING-AND-MOBILE
- agapae.info ETHAN-ALLEN-BABY-CRIB
| Server Location | |
| Infrastructure Amsterdam Netherlands 52.35, 4.92 | |
Infrastructure Amsterdam is the location of the Apache server. Its IP Number is 188.121.45.128. Its 2 nameservers are ns69.domaincontrol.com, and ns70.domaincontrol.com.
IP: 188.121.45.128
Web Server: Apache
Encoding: utf-8
| PING (188.121.45.128) 56(84) bytes of data. | |
| 64 bytes from n1nwhg033.shr.prod.ams1.secureserver.net (188.121.45.128): icmp_req=1 ttl=117 | 115 ms |
| 64 bytes from n1nwhg033.shr.prod.ams1.secureserver.net (188.121.45.128): icmp_req=2 ttl=117 | 114 ms |
| 64 bytes from n1nwhg033.shr.prod.ams1.secureserver.net (188.121.45.128): icmp_req=3 ttl=117 | 114 ms |
| --- ping statistics --- | |
| 3 packets transmitted, 3 received, 0% packet loss, time 2000ms | |
| rtt min/avg/max/mdev = 114.637/114.903/115.217/0.239 ms | |
| rtt min/avg/max/mdev = 114.637/114.903/115.217/0.239 ms |
A ping speed test response, is timed at 115 ms.
| Server Setup | |
| Date: | -- |
|---|---|
| Server: | Apache |
| Transfer-Encoding: | chunked |
| Content-Type: | text/html |